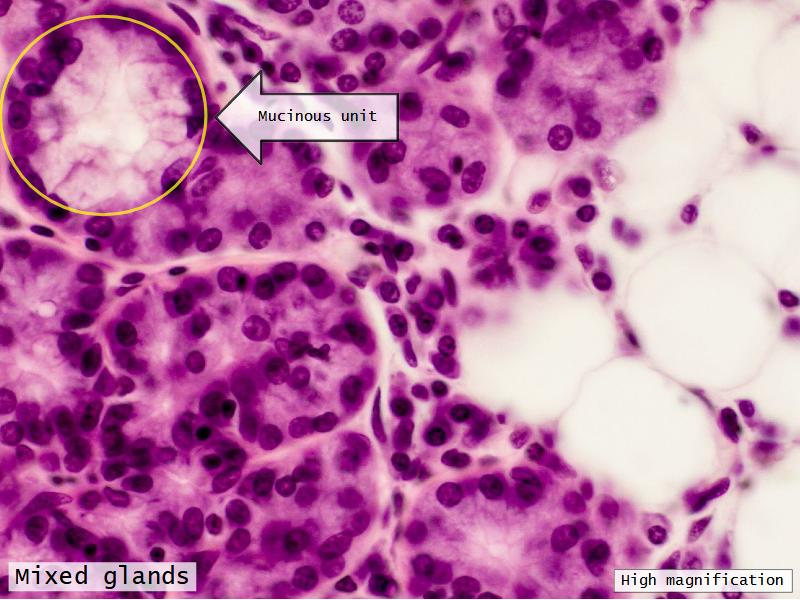

Respiratory System

Help
- esc key shows all the slides
- arrows left right advance the slide
- mobile device swipe left right
- slides can go left-right and up-down
- ? gives instant help
- menu bottom left
- Have a pen & paper ready
- Answer every question
- Attempt to label all slides
- Mark your answer after answering
- Elaborate on each answer
- Add relevant clinical content
- If you have trouble, ask - you know where
Calibration
Community of Truth
What is my answer?What is the correct answer?
I am am wrong, what was my error?
THUS: Find the truth
Philosophy 1
What is the least amount of work I can do so I can get out of here.Philosophy 2
Today and Now I will do something for my future self.

























































































































Reflection
- Is this a good reflection of your knowledge?
- Did you improve on your previous attempt?
- What sections do you need to spend some extra time on?
- Do you need clarification for any specific section?


Concepts
Transitions
External nose > Alveolus- Keep dust and pathogens out
- Let clean air in
- Stay open - do not block air
- Exand and contract = breath
- Make gas exchange possible
Elaborate using anatomy and physiology.
Go with the flow
Trace the air flow of respiratory system starting with the nostrils.What path does a molecule of oxygen take to reach the blood?
What sights will it see along the way?
1. Outside air
2. ??
3. ...
4. Toes
The cardiovascular system needs to be connected to the respiratory system.Path of O2 and CO2
- List complete
- With layers
- And cells
- And function of each
- Make use of annotated drawings and diagrams


What cells are present?










Components of the Blood-Air Barrier?
What other barrier systems are found in the body?
What are the purpose of each of these barrier systems? Connected with physiology will unlock the pathology.

Barriers
- Skin
- Blood-air
- Blood-brain
- Blood-retina
- Blood-thymus
- Blood-testis
- Placental barrier
Function of the nasal cavity?




Function of the nasal cavity?
- Warm
- Moisture
- Filter
- Smell
Slides: Respiratory System
- Slide 71: Nostril
- Slide 72 & 74: Lung
- Slide 73: Trachea
- Slide 108: Olfactory epithelium
- Slide 111: Epiglottis
Nostril









Name three types of contractile cells.




Olfactory epithelium




Epiglottis




Respiratory epithelium
- Pseudostratified
- Ciliated
- Columnar
- Epithelium with
- 4 Cells
- Ciliated columnar cells
- Non-ciliated columnar cells
- Goblet cells
- Basal cells

Trachea


























Bronchi - Transitions
- Intrapulmonary bronchi
- Irregular cartilage
- Respiratory epithelium
- Glands
- Bronchioles
- Smooth muscle REPLACE cartilage
- Ciliated columnar > Ciliated cuboidal
- NO glands - goblet cells -> secretory cells
- Terminal bronchioles
- Smooth muscle
- Ciliated cuboidal epithelium
- Secretory cells
- Respiratory bronchioles
- Conducting -> Respiratory
- Simple cuboidal epithelium
- Secretory cells
- Alveoli
Lungs

























Clara cells
Read more about the use of eponyms.
The End
Save Document
- Click the link above
- Print to PDF
Works best using Google Chrome
Others Browser YMMV